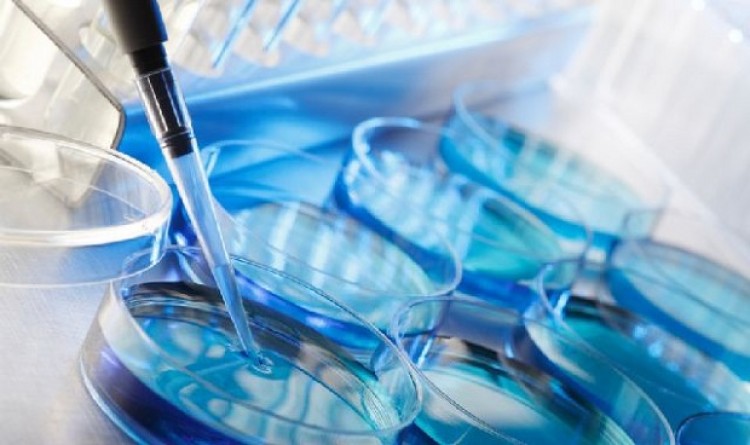

Un procedimiento mínimamente invasivo que consiste en una pequeña incisión a nivel del endometrio, de envergadura similar a la de una biopsia, realizado en forma ambulatoria previamente al tratamiento de fertilización asistida, permitiría mejorar las chances de alcanzar un embarazo. Se denomina “injuria endometrial” y recientemente, en el marco del Congreso de la Sociedad Europea de Reproducción Humana y Embriología (ESHRE, por sus siglas en inglés), se presentó un metaanálisis que demostró duplicar las probabilidades de éxito de los tratamientos.La investigación[1], liderada por la Dra. Sarah Lensen, incluyó una recopilación de ocho estudios randomizados que involucraron a 1180 pacientes, en los que se compararon los resultados en casos de injuria, placebo y no intervención. Entre las conclusiones del trabajo, se encontró que la realización de este procedimiento podría elevar las posibilidades de embarazo de 9 por ciento a entre el 14 y el 28 por ciento. Incluso, los investigadores sugieren que también podría realizarse en algunos tratamientos de fertilización mínimamente invasivos.En nuestro país, el procedimiento es utilizado por algunos centros, como por ejemplo el Centro Especializado en Reproducción (CER). La Dra. Ester Polak de Fried, médica especialista en Fertilidad y directora de dicha institución, explicó que “basándonos en las investigaciones disponibles, desde hace algunos años decidimos implementar la técnica en aquellas pacientes con fallas de implantación reiteradas, manejándonos dentro de un protocolo previamente establecido. Los resultados fueron muy satisfactorios, tanto es así que últimamente integra la rutina de los procedimientos complementarios que realizamos cuando está indicada”.Otras investigaciones, una realizada en 2003 liderada por el Dr. Amihai Barash y otra en 2007 presidida por el Dr. Arieh Raziel, ya habían abordado esta temática y encontraron resultados similares. Gracias a estos estudios previos y al recientemente presentado, la injuria endometrial está siendo cada vez más utilizada a nivel mundial: un comunicado reciente del ESHRE indica que el 83% de los profesionales de Australia, Nueva Zelandia y el Reino Unido, recomiendan la realización de esta técnica antes de iniciar una fertilización in vitro.En cuanto a la intervención en sí, la Dra. Polak, que también es docente autorizada de Ginecología y Endocrinología Reproductiva de la UBA, comentó que “en nuestro protocolo decidimos efectuar el procedimiento en forma previa a la fertilización in vitro, inmediatamente después de realizar una prueba de catéter para la futura transferencia del embrión. La técnica no necesita anestesia ni internación, se realiza en pocos minutos bajo control ecográfico y no produce molestias. La paciente se va a su casa caminando y retoma inmediatamente sus quehaceres habituales”.Uno de los mayores desafíos de la medicina reproductiva es resolver el problema de un porcentaje de pacientes que, pese a realizarse distintos tratamientos, no logran alcanzar el embarazo. Frente a estas situaciones, denominadas ‘Fallas Reiteradas de Implantación’, los especialistas analizan todos los factores posibles antes de realizar la técnica de fertilización, a fin de optimizar las chances de un resultado positivo. La ‘injuria endometrial’ forma parte de los procedimientos complementarios que pueden o no llevarse a cabo en el marco de un tratamiento de reproducción asistida.Distintas hipótesis intentaron explicar el porqué de la efectividad de la injuria. Una de ellas postula que es una forma de generar una reacción inflamatoria que incrementa la receptividad del endometrio. “Existe un verdadero "diálogo" entre el embrión que llega y el endometrio, en el que intervienen numerosos componentes moleculares y enzimas, -sostuvo Ester Polak-; agregando que el proceso de implantación dependerá de una correcta interacción entre las señales enviadas por el embrión y el endometrio durante una corta ventana de tiempo”.Sin embargo, los especialistas llaman a ser cautos y esperan nuevas investigaciones que confirmen estos primeros resultados. “Se necesitan aún más estudios prospectivos y randomizados para conocer mejor la efectividad de la técnica y los mecanismos de acción implicados. Mientras tanto, hasta tener una definición basada en evidencia más robusta, continuamos en la incesante búsqueda de procedimientos que nos ayuden a lograr altas tasas de nacidos vivos entre nuestros pacientes”, concluyó la Dra. Polak.
Un procedimiento mínimamente invasivo que consiste en una pequeña incisión a nivel del endometrio, de envergadura similar a la de una biopsia, realizado en forma ambulatoria previamente al tratamiento de fertilización asistida, permitiría mejorar las chances de alcanzar un embarazo. Se denomina “injuria endometrial” y recientemente, en el marco del Congreso de la Sociedad Europea de Reproducción Humana y Embriología (ESHRE, por sus siglas en inglés), se presentó un metaanálisis que demostró duplicar las probabilidades de éxito de los tratamientos.La investigación[1], liderada por la Dra. Sarah Lensen, incluyó una recopilación de ocho estudios randomizados que involucraron a 1180 pacientes, en los que se compararon los resultados en casos de injuria, placebo y no intervención. Entre las conclusiones del trabajo, se encontró que la realización de este procedimiento podría elevar las posibilidades de embarazo de 9 por ciento a entre el 14 y el 28 por ciento. Incluso, los investigadores sugieren que también podría realizarse en algunos tratamientos de fertilización mínimamente invasivos.En nuestro país, el procedimiento es utilizado por algunos centros, como por ejemplo el Centro Especializado en Reproducción (CER). La Dra. Ester Polak de Fried, médica especialista en Fertilidad y directora de dicha institución, explicó que “basándonos en las investigaciones disponibles, desde hace algunos años decidimos implementar la técnica en aquellas pacientes con fallas de implantación reiteradas, manejándonos dentro de un protocolo previamente establecido. Los resultados fueron muy satisfactorios, tanto es así que últimamente integra la rutina de los procedimientos complementarios que realizamos cuando está indicada”.Otras investigaciones, una realizada en 2003 liderada por el Dr. Amihai Barash y otra en 2007 presidida por el Dr. Arieh Raziel, ya habían abordado esta temática y encontraron resultados similares. Gracias a estos estudios previos y al recientemente presentado, la injuria endometrial está siendo cada vez más utilizada a nivel mundial: un comunicado reciente del ESHRE indica que el 83% de los profesionales de Australia, Nueva Zelandia y el Reino Unido, recomiendan la realización de esta técnica antes de iniciar una fertilización in vitro.En cuanto a la intervención en sí, la Dra. Polak, que también es docente autorizada de Ginecología y Endocrinología Reproductiva de la UBA, comentó que “en nuestro protocolo decidimos efectuar el procedimiento en forma previa a la fertilización in vitro, inmediatamente después de realizar una prueba de catéter para la futura transferencia del embrión. La técnica no necesita anestesia ni internación, se realiza en pocos minutos bajo control ecográfico y no produce molestias. La paciente se va a su casa caminando y retoma inmediatamente sus quehaceres habituales”.Uno de los mayores desafíos de la medicina reproductiva es resolver el problema de un porcentaje de pacientes que, pese a realizarse distintos tratamientos, no logran alcanzar el embarazo. Frente a estas situaciones, denominadas ‘Fallas Reiteradas de Implantación’, los especialistas analizan todos los factores posibles antes de realizar la técnica de fertilización, a fin de optimizar las chances de un resultado positivo. La ‘injuria endometrial’ forma parte de los procedimientos complementarios que pueden o no llevarse a cabo en el marco de un tratamiento de reproducción asistida.Distintas hipótesis intentaron explicar el porqué de la efectividad de la injuria. Una de ellas postula que es una forma de generar una reacción inflamatoria que incrementa la receptividad del endometrio. “Existe un verdadero "diálogo" entre el embrión que llega y el endometrio, en el que intervienen numerosos componentes moleculares y enzimas, -sostuvo Ester Polak-; agregando que el proceso de implantación dependerá de una correcta interacción entre las señales enviadas por el embrión y el endometrio durante una corta ventana de tiempo”.Sin embargo, los especialistas llaman a ser cautos y esperan nuevas investigaciones que confirmen estos primeros resultados. “Se necesitan aún más estudios prospectivos y randomizados para conocer mejor la efectividad de la técnica y los mecanismos de acción implicados. Mientras tanto, hasta tener una definición basada en evidencia más robusta, continuamos en la incesante búsqueda de procedimientos que nos ayuden a lograr altas tasas de nacidos vivos entre nuestros pacientes”, concluyó la Dra. Polak.







Discussion about this post